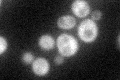
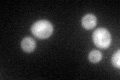
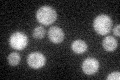

View description
Cytoplasmic protein required for replication of Brome mosaic virus in S. cerevisiae, which is a model system for studying replication of positive-strand RNA viruses in their natural hosts
Localization:
Intensity:
Fold change:
Significance:
-
C’ GFP library in SD
cytosol37.28 -
N' NOP1pr-GFP in SD

cytosol35.5247 -
N' TEF2pr-mCherry in SD

cytosol46.7597 -
N' NATIVEpr-GFP in SD

below threshold23.9228 -
N' TEF2pr-VC and Cyto-VN in SD

#N/A0 -
C’ GFP library in SD+DTT
cytosol37.461No -
C’ GFP library in SD+H2O2

cytosol45.481.22No -
C’ GFP library in Starvation Media
cytosol34.420.92No -
C’ GFP library on the background of Pup2-DaMP

N/A -
C’ GFP library on the background of CCT mutant

N/A0N/AYes
